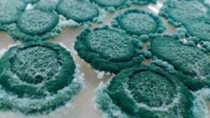

Agricultura
Soluções BASF para Cultivo de Hortaliças
Doenças como oídio, requeima e do gênero Alternaria prejudicam o cultivo de hortaliças. Confira as soluções integradas e sustentáveis da BASF!
O oídio é uma doença facilmente encontrada nas regiões produtoras de hortaliças do Brasil. A ocorrência é mais expressiva nos períodos de baixa umidade relativa do ar e de altas temperaturas. Os primeiros sintomas são verificados com maior intensidade na fase do florescimento dos cultivos de hortaliças, podendo provocar desfolha e consequentemente a redução da qualidade e produtividade das culturas. Assim, algumas medidas como a irrigação por aspersão, a escolha de variedades resistentes, uma correta adubação, controle cultural, e o uso de fungicidas químicos de alto desempenho garantem a sanidade das lavouras.
Outra importante doença para os cultivos de hortaliças é a do gênero Alternaria. A sua incidência é maior quando a temperatura e umidade são elevadas. Em casos severos, o fungo pode causar a desfolha reduzindo a produtividade e qualidade além de expor as hortaliças ao sol, provocando queimaduras e inviabilizando a comercialização de cultivos como batata, cebola e cenoura. A requeima também merece atenção dos produtores de hortaliças, principalmente da batata e tomate. Sob clima úmido e fresco, o fungo desta doença pode sobreviver de um ano para o outro, e é disseminado pelo vento, água e insetos.
Para um controle eficiente não deixe de fazer o manejo preventivo e o monitoramento do clima. Conheça também os herbicidas, inseticidas e reguladores de crescimento para as diferentes culturas de hortaliças oferecidos pela BASF.
Confira as soluções BASF para a cultura de hortaliças
ESPALHANTE ADESIVO
Assist®
Break Thru®
HERBICIDAS
Uso exclusivamente agrícola. Aplique somente as doses recomendadas. Descarte corretamente as embalagens e restos de produtos. Incluir outros métodos de controle do programa do Manejo Integrado de Pragas (MIP) quando disponíveis e apropriados. Restrições temporárias no estado do Paraná: Cabrio® Top para Alternaria porri e Puccinia allii no alho; Caramba® 90 para Puccinia horiana para Crisântemo, Phaeoisariopsis griseola para Feijão, Uromyces appendiculatus para Feijão-vagem, Diplocarpon rosae para Rosa, Puccinia graminis para Trigo e Phakopsora pachyrhizi para Soja; Forum® Plus para Peronospora sparsa para Rosa; Imunit® para a cultura arroz; Polyram® DF para o alvo Alternaria porri no alho, Alternaria dauci na cenoura, Botryosphaeria dothidea na maçã, Pseudoperonospora cubensis para melancia e melão, Alternaria solani para o tomate; Verismo® para o alvo Grapholita molesta na maçã, Cryptoblades gnidiella na uva, Helicoverpa armígera na soja e no tomate. Registro MAPA: Acrobat® MZ nº 02605; Cabrio® Top nº 01303; Cantus® nº 07503; Caramba® 90 nº 01601; Collis® nº 01804; Delan® nº 01818604; Fastac® 100 nº 002793; Forum® nº 01395; Forum® Plus nº 03502; Heat® nº 01013; Herbadox® 400 EC nº 015907; Imunit® nº 08806; Nomolt® 150 nº 01393; Orkestra® SC nº 08813; Pirate® nº 05898; Polyram® DF nº 01603; Regent® Duo nº 12411; Stroby® SC nº 03198; Verismo® nº 18817; Break Thru® nº 003898 e Assist® nº 01938789.